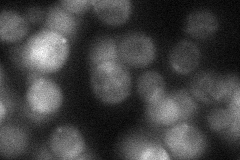
YGR286C
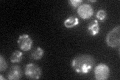
YGR286C

View description
Biotin synthase, catalyzes the conversion of dethiobiotin to biotin, which is the last step of the biotin biosynthesis pathway; complements E. coli bioB mutant
Localization:
Intensity:
Fold change:
Significance:
-
C’ GFP library in SD

mitochondria66.47 -
N' NOP1pr-GFP in SD

mitochondria100.446 -
N' TEF2pr-mCherry in SD

mitochondria110.003 -
N' NATIVEpr-GFP in SD
cytosol,punctate27.3569 -
N' TEF2pr-VC and Cyto-VN in SD

#N/A0 -
C’ GFP library in SD+DTT

mitochondria34.450.51Yes -
C’ GFP library in SD+H2O2

mitochondria82.91.24No -
C’ GFP library in Starvation Media
mitochondria51.210.77No -
C’ GFP library on the background of Pup2-DaMP

mitochondria -
C’ GFP library on the background of CCT mutant

mitochondria69.08411.03912No
